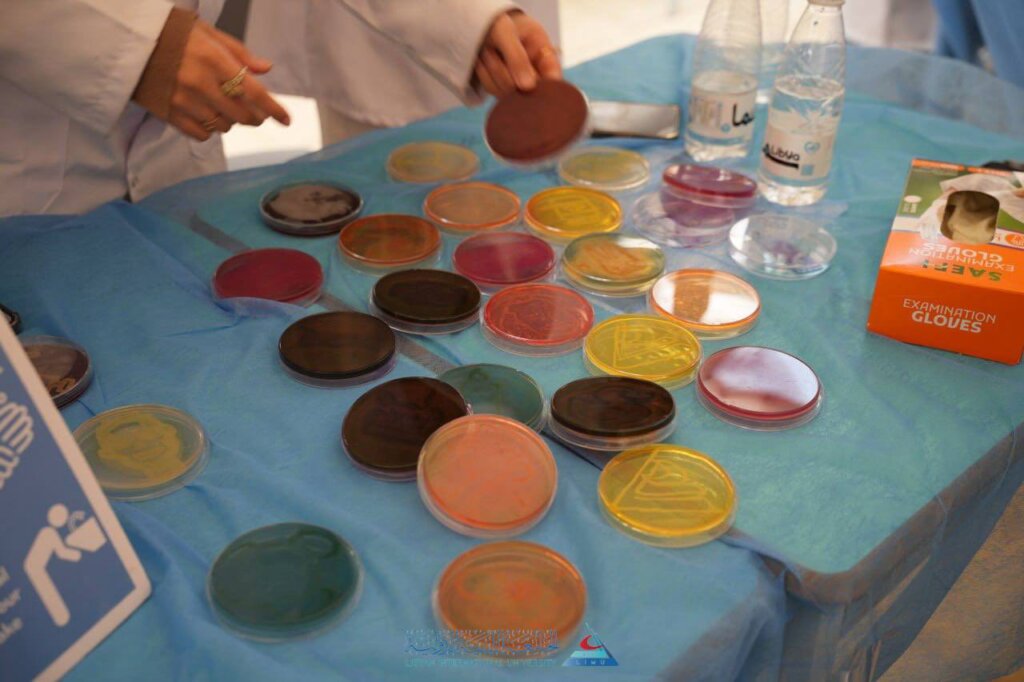

تماماً كما قال السيد مدير برنامج العلوم الطبية الأساسية الأستاذ الدكتور عبد الله المنصوري في كلمته المبهجة في افتتاح فعاليات النسخة العاشرة لليوم العلمي للبرنامج صباح أمس الخميس 2026/2/12 “إن وصولنا للمحطة العاشرة في مسيرة تنظيم وإحياء اليوم العلمي للكلية ثم البرنامج، يحمل الكثير من المعاني المكتنزة بالكثير من الفخر ،بطلابنا و بتلكم المخرجات التي مرّت من هنا ذات يوم ،ثم انضمت لسوق العمل، أو واصلت دراستها العليا في الداخل والخارج ، لتكون علامةً فارقةً في العطاء والأداء والنبوغ والتميُّز”
في النسخة العاشرة تجلَّت قدرات طلاب برنامج طلاب العلوم الطبية الأساسية، وجهروا بمهاراتهم، واستعرضوا مااكتسبوه من قدرات وخبرات ومعارف خلال دراستهم الأكاديمية.فكان كل ركن عنواناً للإبداع وكانت كل زاوية دليلاً على المُكنة والابتكار.
ويتعدى هذا اليوم كونه مناسبة وبراحاً ،يتيح للطلاب تقديم تصوراتهم وأفكارهم ومقترحاتهم،إلى (مناسبة تأهيلية)لإعداد القيادات الشابة التي تتولى إدارة هذا (اليوم) في كل عام.
إن برنامج العلوم الطبية الأساسية هو (الجواهرجي)الذي يشكِّل هوية مخرجات الدولية.